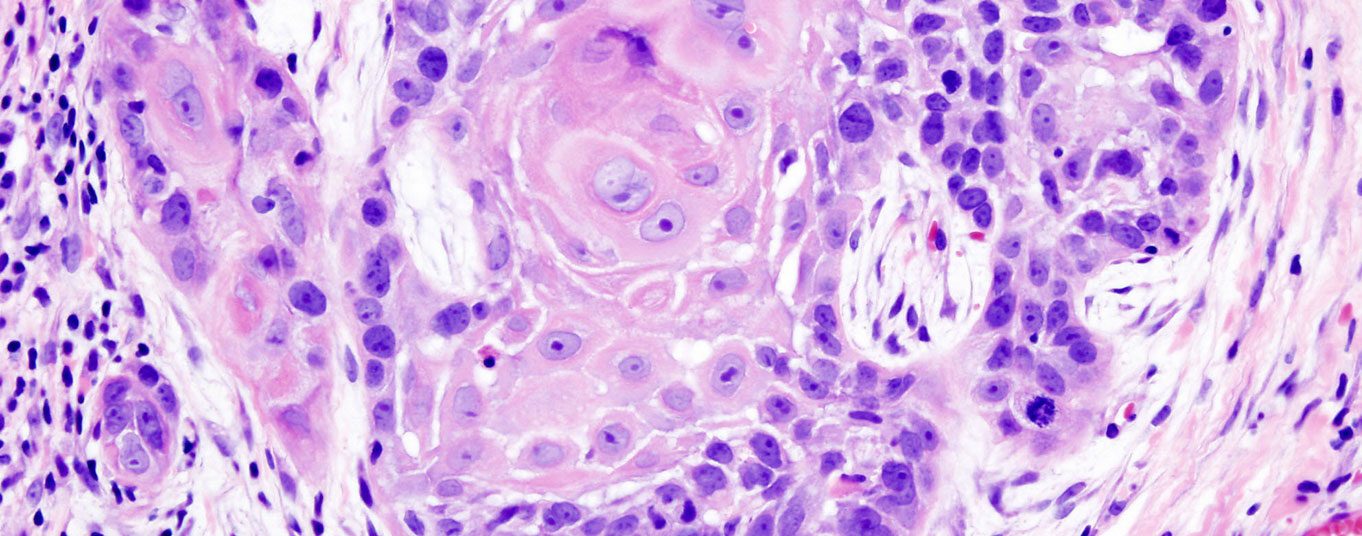
plattenepitelkarzinom_wikimedia

Eine Prognose, welche aktinischen Keratosen (AK) sich im Verlauf in ein Plattenepithelkarzinom (PEK) entwickeln, ist aktuell nicht möglich. Studienbefunde zeigen, dass sich auch aus AK Grad I invasive PEK bilden können. Deshalb sollten AK grundsätzlich behandelt werden. Eine frühzeitige Therapie verhindert nicht nur die Entstehung potenziell schwerwiegend verlaufender Hauttumore, sondern kann auch die Lebensqualität verbessern.
Autoren
- Mirjam Peter, M.Sc.
Publikation
- DERMATOLOGIE PRAXIS
- InFo ONKOLOGIE & HÄMATOLOGIE
Related Topics
Dir könnte auch gefallen
- Vom Symptom zur Diagnose
Pneumologie – Covid-19: ein Rückblick
- Altersbedingte neurokognitive Störungen
Neuroprotektive Wirkungen des Ginkgo-biloba-Extrakts
Wie Herkunft und Wohnort den CF-assoziierten Diabetes fördern
- Pankreaskarzinom
Innovative Früherkennung mit Fokus auf Liquid Biopsy und KI
- Vom Symptom zur Diagnose
Abdominalschmerz – Prostataabszess
- Asthma in der Schwangerschaft
Bis zu 40% erleiden Symptomverschlechterung während der Gravidität
- Vom Symptom zur Diagnose
Komplizierte Nierenzysten
- Schweres Asthma und CRSwNP